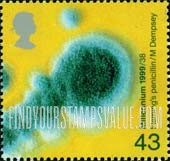

Great Britain (United Kingdom): Health Care - Discovery of Penicillin, by Alexander Fleming 43p Multicolored
- Land Great Britain
-
Bezeichnung
?43pDer Nennwert einer Briefmarke, gewöhnlich auf Briefmarken gedruckt.— Glossar
-
Farbe
?MulticoloredUrsprüngliche Katalogfarbe der Briefmarke.
-
Druckmethode
?PhotogravureMethode des Druckprozesses vom Designs auf Papier
-
Perforation
?13.75x14Löcher, die zwischen Marken geschlagen sind, um das leichtere Trennen zu machen
-
Wasserzeichen
?UnwatermarkedEin Muster, das in Papier während des Produktionsprozesses eingebettet ist
-
Ausgabedatum
?Datum auf einer Briefmarke oder Entwertung für gestempelte Briefmarken entspricht nicht erforderlich dem tatsächlichen Datum der Briefmarkenausgabe.
![]()
-
#
?Katalognummer der Briefmarke
![]()
-
Price
![]()
-
Price
![]()


